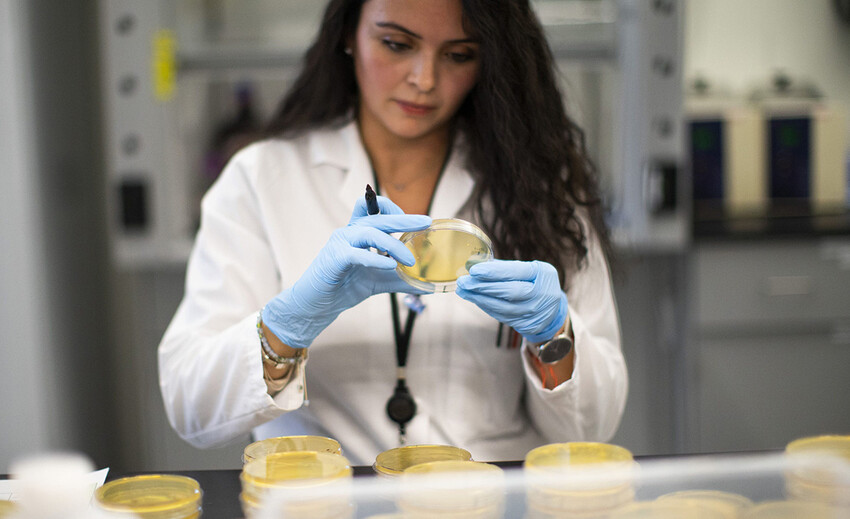
Твиндемия

Этот осенний сезон может привести к смертельной комбинации двух угроз, двум эпидемиям одновременно или, как её уже успели окрестить учёные, «твиндемии». Сезон простуды и гриппа в Северном полушарии должен начаться в октябре. И пока никто точно не может предсказать, что произойдёт, когда грипп встретится с COVID-19. Медики призывают людей готовиться к худшему — вместе эти две болезни могут поставить под угрозу всю систему здравоохранения.
Для статистики: грипп в Соединенных Штатах ежегодно уносит жизни от 12 000 до 61 000 человек, в больницу с тяжёлой формой попадают от 140 000 до 810 000 человек. Что будет в сочетании со второй волной коронавируса, даже предположить сложно. Кроме того, важно не забывать об одном новом факторе: «Люди всё больше устают от ношения маски, социального дистанцирования и гигиены рук», — говорит Жанна Марраццо, руководитель отдела инфекционных заболеваний Университета Алабамы в Бирмингеме, и с ней сложно не согласиться.
Эксперты по инфекционным заболеваниям опасаются сочетания гриппа и коронавируса не только из-за риска перегруженности систем здравоохранения. Чтобы выяснить, болен человек гриппом или коронавирусом, у которых очень похожие симптомы, потребуется провести тестирование на оба вируса. При этом получение результатов теста на COVID-19 часто происходит медленно. А некоторые люди могут и вовсе заразиться несколькими вирусами одновременно, что только усугубит симптомы.

COVID-19 сильнее?
При этом в Южном полушарии, где сезон гриппа приходится на середину года, всё прошло по относительно спокойному сценарию. Обычно случаи заболеваний начинаются тут в мае, а пик сезона приходится на июль и заканчивается примерно в октябре. Последние пять-шесть лет сезоны гриппа в Австралии были напряжёнными, 2020-й год тоже был неважным, но, как говорят местные медики, грипп как будто отступил под натиском COVID-19 и не «бушевал», как обычно. Так, в Австралии с апреля по июль только 33 из 60 031 протестированных получили положительные результаты анализов на грипп. Гриппа также почти не было в Южной Африке, Чили и ряде других стран полушария.
Возможно, в этом помогли закрытые границы. Так, в Австралии туристы попросту не завозили в страну новые виды гриппа. Закрытие школ, части предприятий, офисов, ношение масок, социальное дистанцирование и мытьё рук — все эти меры, принятые для предотвращения распространения COVID-19, также могли помочь не допустить традиционную вспышку гриппа.
«Мы ожидали вспышку гриппа и респираторно-синцитиального вируса после того, как в Австралии снова открылись школы, но этого не произошло. Вместо этого мы диагностируем риновирус, который вызывает простуду», — говорит Канта Суббарао, вирусолог, возглавляющий Центр сотрудничества Всемирной организации здравоохранения по справочным материалам и исследованиям гриппа в австралийском Мельбурне.

Меньше путешествий — легче эпидемия
Долгое время поездки и перелёты были ограничены и в Северном полушарии. Как считает бывший директор Центра по контролю и профилактике заболеваний США Том Фриден, грипп «распространяется по всему миру, когда люди путешествуют». Так, начиная с 5 апреля, менее 1% тестов на грипп в США выявили вирус, а количество положительных случаев в межсезонье находится на историческом минимуме. Исследователи пишут, что если социальное дистанцирование и другие меры по сдерживанию COVID-19 останутся в силе, сезон гриппа в Соединенных Штатах может затянуться или отложиться.

Грипп непредсказуем
Ричард Уэбби, вирусолог из Детской исследовательской больницы Св. Джуда в Мемфисе, штат Теннеси, участвует в исследованиях, которые помогают предсказать, какие штаммы гриппа будут доминировать в этом сезоне. Это нужно, чтобы подготовить нужный состав вакцины. Так вот Уэбби и другие исследователи гриппа неоднократно наблюдали одну закономерность: когда возникает новый штамм пандемического гриппа, он вытесняет прежний штамм. Например, когда появился пандемический штамм гриппа H1N1 в 2009 году, другой штамм гриппа H1N1, который циркулировал с 1977 года, попросту исчез. По словам Уэбби, SARS-CoV-2 — вирус, вызывающий COVID-19, — и грипп будут конкурировать за заражение хозяев, что может привести к тому, что один вирус вытеснит другой.
«Мне трудно поверить, что грипп и COVID будут распространяться одновременно. Я думаю, что один из них будет доминировать. Я не могу сказать, какой именно. Если бы меня попросили сделать ставку, какая болезнь будет преобладать, я бы поставил поровну на каждую сторону. Вероятно, обе эти болезни не станут массовыми убийцами, но я легко могу ужасно ошибаться», — говорит вирусолог.
Впрочем, в битве за хозяев иногда побеждают оба вируса, заражая человека одновременно. Так, Балрадж Сингх, работающий в медицинском центре Университета Св. Джозефа в Патерсоне, штат Нью-Джерси, обнаружил, что трое его пациентов были инфицированы SARS-CoV-2 и гриппом одновременно. При этом Сингх и его коллеги не могут сказать, протекала ли двойная болезнь хуже. В итоге всех пациентов выписали.

Вероятно, подобные случаи будут редкостью, говорит Дэвид Моренс, вирусолог и врач-инфекционист, старший научный советник директора Национального института аллергии и инфекционных заболеваний США в Бетесде, штат Мэриленд. Согласно одному анализу, только около 3% пациентов с COVID-19 одновременно были инфицированы другим вирусом. Наиболее частыми спутниками коронавируса были RSV и грипп A.
«Невозможно заразиться вирусными инфекциями одновременно или в быстрой последовательности, но, как правило, заражение одной вирусной инфекцией затрудняет заражение другой», — говорит Моренс.

Активизация иммунитета
Один вирус с трудом «берёт» уже заражённый другим вирусом организм потому, что вирусные инфекции, как правило, активизируют общую защитную иммунную систему. Поимка одного вируса вызывает тревогу и в течение короткого периода после инфекции, может быть, от пары недель до месяцев, иммунная система находится в состоянии повышенной готовности. Это противодействие вирусным захватчикам отличается от особого вида иммунитета, который возникает в результате выработки антител против определённого вируса, но всё же может быть полезно.
В результате этого некоторые учёные предполагают, что вакцины против туберкулеза, кори или полиомиелита, содержащие живой ослабленный вирус или бактерии, могут дать некоторую степень защиты и от COVID-19, в целом укрепляя иммунную систему. Вероятно, поэтому официальные лица здравоохранения призывают людей делать прививки от гриппа, чтобы снизить вероятность заражения обоими вирусами и предотвратить неприятный сезон гриппа.
«Если и есть год, когда действительно нужно сделать прививку от гриппа, сделайте это именно сейчас», — говорит Жанна Марраццо, директор отделения инфекционных заболеваний Университета Алабамы в Бирмингеме.
Источник фото: Gettyimages
Читайте самое интересное от Mainstyle на ЯНДЕКС.ДЗЕН







Комментарии